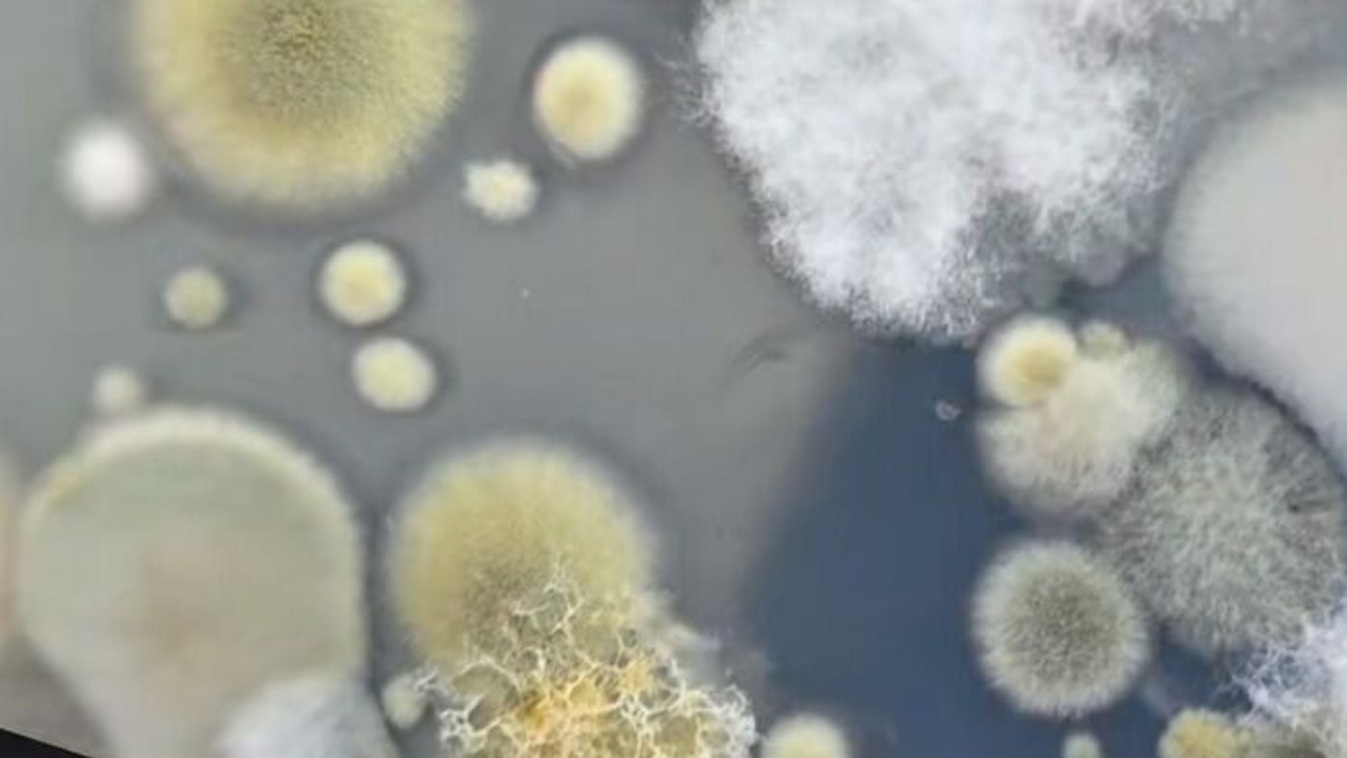

Itt a nagy hóteszt: most kiderül, mennyire tiszta a frissen hullott hó
Újabb érdekes kísérlettel jelentkezett Gyuris Rita.
Portfóliónk minőségi tartalmat jelent minden olvasó számára. Egyedülálló elérést, országos lefedettséget és változatos megjelenési lehetőséget biztosít. Folyamatosan keressük az új irányokat és fejlődési lehetőségeket. Ez jövőnk záloga.